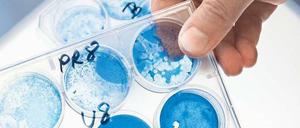
Umstrittene Grundlagenforschung. Wer Impfungen oder Gegenmittel gegen die Vogelgrippe entwickeln will, muss die Viren erst verstehen.

Der Fleischskandal könnte in Frankreich begonnen haben, in dem Land, wo Pferdefleisch als Spezialität gilt und normalerweise vollkommen unproblematisch verzehrt werden kann. Jetzt wurden auch Spuren bei einem brandenburgischen Hersteller entdeckt.

Der Fleischskandal könnte in Frankreich begonnen haben, in dem Land, wo Pferdefleisch als Spezialität gilt und normalerweise vollkommen unproblematisch verzehrt werden kann. Jetzt wurden auch Spuren bei einem brandenburgischen Hersteller entdeckt.

Auch bei Aldi und Lidl werden jetzt Produkte aus den Regalen genommen, in denen falsch deklariertes Pferdefleisch enthalten ist. Die EU-Staaten einigten sich zwischenzeitlich darauf, mit Gentests nach Pferdefleisch zu fahnden.

Noch immer sind die Folgeschäden der deutschen Zwangsteilung nicht behoben, sagt unser Leser Lutz Rackow. Auch deshalb sind viele leistungsfähige Ostdeutsche in den Westen gegangen, vor allem nach Bayern und Baden-Württemberg - und dort finanzieren sie den Länderfinanzausgleich mit.

Das Theater hat etwas in sich, das nur Glück bringen kann: Die Schauspielerin Gudrun Genest ist gestorben.
Die Potsdamerin Johanna Wanka wird Angela Merkels neue Wissenschaftsministerin. Ein Blick auf eine Frau, die weiß, was sie will und auch als Ministerin in Niedersachsen auf Potsdam geachtet hat

Alle lieben sie. Nina Hoss ist ein Star. Dabei tut die Schauspielerin fast nichts dafür. Außer glänzend zu sein. Jetzt wieder in dem Wettbewerbsfilm „Gold“.
Es sind keineswegs immer nur Osteuropäer. Jetzt deckten Ermittler aus Schleswig-Holstein und Brandenburg einen Fall von gewerbsmäßiger Hehlerei mit Autoteilen in Brandenburg auf.

60 Jahre „Aktion Rose“ – Wut und Trauer sind in Mecklenburg-Vorpommern noch immer nicht verflogen.

„Ich gebe keine Ratschläge, ich reflektiere“, sagt Arthur Engelbert über sein jüngst erschienenes Buch „Help! Gegenseitig behindern oder helfen.

Ein Vierbeiner, der gut klettern konnte, ist der Urahn aller höheren Säugetiere, zu denen auch der Mensch gehört. Ein internationales Forscherteam hat das Tier jetzt unter anderem anhand genetischer Untersuchungen rekonstruiert.
Urteil: Ein Kind hat das Recht zu erfahren, wer sein Vater ist

Das Oberlandesgericht in Hamm hat entschieden, dass Kinder anonymer Samenspender das Recht haben, den Namen ihres Vaters zu erfahren. Zur Entfaltungsfreiheit gehört allerdings auch, dass es ein Ich jenseits von Genen und Abstammung gibt.

Das falsche Krümelmonster hat Wort gehalten – das Wahrzeichen hing vor der Leibniz-Universität in Hannover. Polizisten mit Mundschutz bargen den gestohlenen Gegenstand.

Albrecht Gündel-vom Hofe ist Mathematiker, Musiker und Christ. Seine Spezialität: Er verjazzt Kirchenchoräle.

Über hundert Filmproduktionen buhlen in Berlin um Aufmerksamkeit - darunter Lokalmatadoren wie Barefoot Films oder X-Filme. Aber auch kleine Produzenten drängen nach Berlin - und sind erfolgreich.

Mal schöne Zigeunerin, doch meist verhasste Fremde. Jahrhundertelang. Propaganda brauchte die NS-Vernichtungspolitik nicht mehr. Die tausendjährige Geschichte der Minderheit.

BER-Blues? Hauptstadt der Schande? Achwas! Man muss das positiv sehen: Ah, wie schön ruhig es im sonnigen Süden unserer Hauptstadt ist! Beziehungsweise: war! Denn jetzt fliegt da die Kuh - und wir haben den Soundtrack dazu. Play!

Nach jahrelangen Debatten ist der Weg für die umstrittene Präimplantationsdiagnostik (PID) in Deutschland frei. Eltern können nun ihre Embryonen bald mit Gentests auf schwere Defekte untersuchen lassen.

Der Berliner Chemiker Peter Hegemann schaltet Zellen mit Licht an und aus. Das ermöglicht Einblicke ins Gehirn – und eines Tages vielleicht neuartige Therapien. Die von Hegemann mitentwickelte Methode wird mittlerweile in Hunderten von Labors in aller Welt angewandt.
Lkw-Fahrer streift Sattelzugund flüchtetPotsdam-Mittelmark - Auf einer Raststätte in Richtung Leipzig zwischen den Anschlussstellen Brück und Niemegk ist am Mittwoch gegen 2.10 Uhr ein parkender Sattelzug von einem anderen Lkw beschädigt worden, es entstand ein Schaden von rund 10 000 Euro.

Inge Deutschkron überlebte als Jüdin in einem Versteck in Berlin den Holocaust. Hier dokumentieren wir ihre Rede zum Tag des Gedenkens, die sie am 30. Januar im Deutschen Bundestag hielt, zum 80. Jahrestag von Hitlers Machtübernahme.

Bekommt der Rechtspopulismus in Krisenzeiten neuen Auftrieb? Darüber wurde gestern in der Heinrich Böll-Stiftung diskutiert - mit dem Ergebnis, dass Europa mittlerweile zum Feinbild von Rechtspopulisten wird.

Jon Bon Jovi plaudert am Potsdamer Platz mit Golden-Retriever-Blick über seine Gefühle. Alt wird der 50-Jährige irgendwie nicht

Stahnsdorf/München - „Ich finde es eine Schande, dass so etwas passiert.“ Karl Ernst Tielebier-Langenscheidt, 91 Jahre alter Verleger in München und Urenkel des Verlagsgründers Gustav Langenscheidt, wurde gestern etwas lauter am Telefon, als er von den PNN vom neuerlichen Kupferdiebstahl am Langenscheidt-Mausoleum erfuhr.
Die SPECIALS, die neue Reihe NATIVE mit indigenen Filmen, KULINARISCHES KINO und ein EHRENBÄR für Claude Lanzmann.

Beinahe verstellten all die Saurierskelette den Blick darauf, dass es hier um aktuelle Fragen des Lebens geht. Weshalb es einen wie Johannes Vogel braucht. Seit einem Jahr leitet er das Berliner Naturkundemuseum. Er macht es sichtbar. Und wenn er könnte, schlüge er wohl ein Rad.

Jon Bon Jovi plaudert am Montag am Potsdamer Platz mit Golden-Retriever-Blick über seine Gefühle. Alt wird der 50-Jährige irgendwie nicht.

Der Mann, der die Flugroute über den Wannsee kippte, ist dort in einem Kanuverein. Der Verdacht der Befangenheit wurde gezielt gestreut

Der Mann, der die Flugroute über den Wannsee kippte, ist dort in einem Kanuverein – befangen soll er trotzdem nicht sein.

Die EU plant, zwei Forschungsvorhaben mit je einer Milliarde Euro zu fördern. Ihr Nutzen ist jedoch umstritten.

Unterschiede im Erbgut zeigen, dass das Haustier unter anderem die Fähigkeit erlangte, stärkehaltige Nahrung zu verwerten.

Wissenschaftler entwickeln einen Code, um Erbgut als unverwüstlichen Datenspeicher zu nutzen. Erste Tests mit den Sonetten des englischen Dichters waren bereits erfolgreich.

Immer mehr Vögel überwintern in Nuthe-Nieplitz-Niederung – und sparen sich den langen Flug in den Süden

Als erster Investor von Facebook und Mitgründer von Paypal hat sich Peter Thiel einen Namen gemacht. Auf der DLD-Konferenz in München philosophiert er über die Gesellschaft - und wie wir sie gestalten sollten.
Das Moratorium zur Forschung an veränderten Vogelgrippeviren soll in dieser Woche aufgehoben werden. Internationale Regeln zum Umgang mit solchen Viren gibt es aber noch nicht.

Mehr als Arterhaltung: Im Salon Sophie Charlotte am Gendarmenmarkt schickten Wissenschaftler vieler Disziplinen das Publikum auf eine vergnügliche Suche.
„Grüne Legenden“ vom 12. Januar Herr Lynas behauptet, dass die Wissenschaftsgemeinde die grüne Gentechnik unisono befürworte, diese uneingeschränkt unverzichtbare positive Wirkungen habe und keine negativen bekannt seien.
Ebbe und Flut, die Gebrüder Grimm und Dieter Bohlen: Niedersachsen lebt den Wechsel und liebt seine Gegensätze. Am Sonntag wird hier ein neuer Landtag gewählt.

Bei Roten Feuerameisen entscheidet ein großes "Supergen" für soziales Verhalten darüber, wie viele Königinnen eine Kolonie hat. Die Varianten des sozialen Chromosoms werden ähnlich vererbt wie die Geschlechtschromosomen X und Y beim Menschen.

Genetische Analysen zeigen: Der fünfte Kontinent war weniger isoliert als angenommen. Bereits vor 4000 Jahren gab es eine bedeutende Einwanderungswelle.
öffnet in neuem Tab oder Fenster